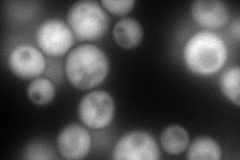
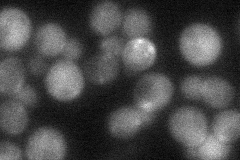

View description
Protein that inhibits activation of Gcn2p, an eIF2 alpha subunit protein kinase, by competing for Gcn1p binding, thus impacting gene expression in response to starvation; has sequence and functional similarity to the mouse IMPACT gene
Localization:
Intensity:
Fold change:
Significance:
-
C’ GFP library in SD

cytosol38.58 -
N' NOP1pr-GFP in SD
cytosol212.746 -
N' TEF2pr-mCherry in SD

missing0 -
N' NATIVEpr-GFP in SD
cytosol37.6407 -
N' TEF2pr-VC and Cyto-VN in SD

#N/A0 -
C’ GFP library in SD+DTT

cytosol39.211.01No -
C’ GFP library in SD+H2O2

cytosol36.520.94No -
C’ GFP library in Starvation Media

cytosol29.760.77No -
C’ GFP library on the background of Pup2-DaMP

cytosol -
C’ GFP library on the background of CCT mutant

cytosol37.57590.973713No
